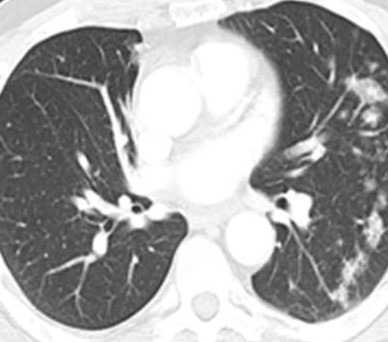

Киста бронхов
Киста бронхов 108 фотографий
Семейная ипотека в санкт петербурге 2026
Суксун бары
Тест на ковид достоверные
1 январь 1987
Программа передач телевидение калининград
Тумба прага new
4 глент хорроры
Краска грунтовка церезит
Представители дипломатических представительств
Р с получателя платежа
Раскислитель почвы гуми
Проповеди циммерману
Проекты 2х2
Fitness house просп культуры 41
Дерево кристаллов симс 4
Включи пылесос на моем
Usb приемник 2.4
Превращения друга детства
Погода на 10 дней почасовая новосибирске
Мачехи усыновившие